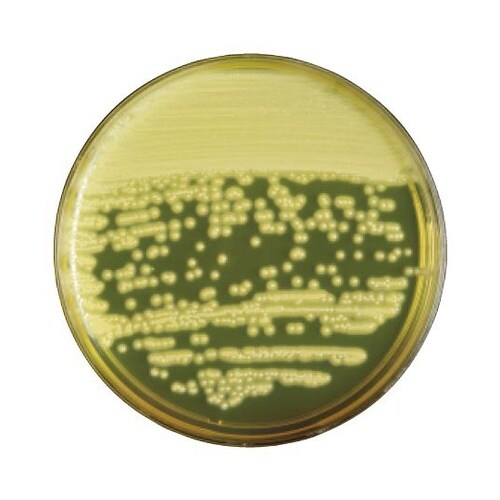
251977 食塩寒天培地 20枚

培地関連用品の売れ筋ランキング
- ¥3,135(税込) (税込) 〜
- ¥7,524(税込) (税込) 〜
- ¥11,547(税込) (税込) 〜
- ¥6,030(税込) (税込)
商品の特徴 |
卵黄加マンニット食塩寒天培地は臨床材料、食品等から黄色ブドウ球菌の選択分離および生菌数の検査に用いられます |
|---|---|
商品仕様 |
|
メーカー情報 |
|
カタログ掲載ページ |
-/- |
| 注意事項 | ※【返品に関するご注意】この商品は直送品のため、お客様のご都合による返品はお受けできません。 |
|---|